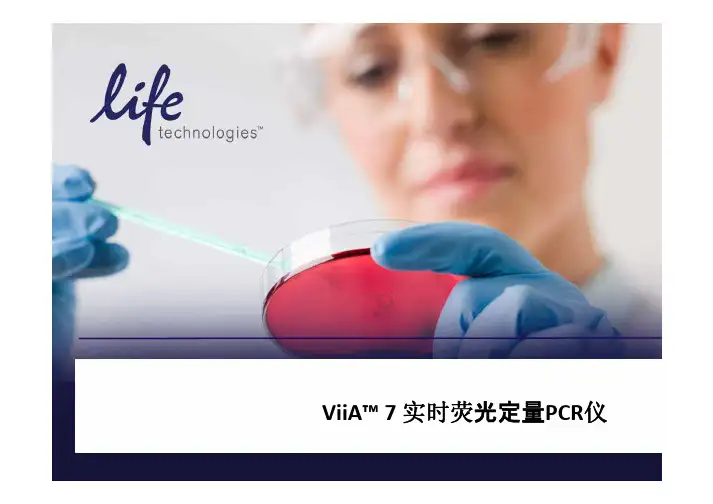

实时荧光定量PCR仪ViiA7操作步骤
- 格式:doc
- 大小:174.50 KB
- 文档页数:3

荧光定量PCR仪操作流程1、开启电脑,并打开Smart Cycler开关,启动Smart软件,系统用户名为Smart,密码为Cycler。
若Create Run 图标非灰色,表明机器已与电脑连接,否则应重新连接,直至Create Run 图标变亮。
2、定义一个程序⑴. 点击Define Protocols 图标。
⑵. 点击New Protocols 图标。
⑶. 输入一个独特的程序名。
⑷. 输入热循环参数。
⑸.点击Save Protocol按钮。
3、创建运行⑴. 点击Create Run 图标。
⑵. 输入一个Run Name。
⑶. 选择Dye Set。
⑷. 点击Add/Remove Site按钮⑷a. 突出一个程序名。
⑷b. 突出位点。
⑷c.点击右箭头。
⑷d.重复⑷a-⑷c步骤直到所有程序和点都被选定。
⑸.点击OK。
⑹.点击Start Run按钮。
4、实时监控反应过程(这一步可省)5、实验完毕,分析实验结果运行开始后,程序会自动切换到View Results栏。
在运行过程中,用户能实时监控温度和光学数据,选择图表,分析设置和样品类型信息。
在运行完成前后及运行期间,分析设置、图表和样品类型信息可以改变。
运行过程中,可以查看存在电脑中的以前的运行。
6、保存并输出实验数据⑴点击View Results显示栏的Export按钮。
⑵检查输出数据类型。
⑶点击Export Data根目录里的Export按钮。
⑷从Look In下拉菜单里选择一个文件夹。
程序默认为Smart Cycler文件夹里的Export文件夹。
⑸.输入一个文件名或接受一个默认的文件名,点击Save。
生物技术中心仪器管理人:李红兵2006年10月15日。

荧光定量仪操作指南1.准备工作在使用荧光定量仪之前,需要进行一些准备工作:-打开仪器电源,并接通仪器的电源线。
-启动仪器,并等待其自检完成。
-检查仪器所需的配件是否齐全,如荧光管、滤光片等。
2.校准仪器在进行荧光定量测量之前,需要对仪器进行校准,以确保测量结果的准确性。
校准通常包括两个步骤:-波长校准:使用标准荧光溶液,根据其发射波长设置仪器的激发和发射波长。
-亮度校准:使用标准荧光溶液,根据其知名的荧光强度设置仪器的亮度。
3.准备样品在测量样品之前,需要进行一些准备工作:-根据测定要求,选择合适的荧光染料,并将其溶解在适当的溶剂中。
-在样品舱中选择合适的载体,如荧光底板或石英反射板,并将样品涂覆在载体上。
4.进行测量在开始测量之前,需要进行一些操作:-打开样品舱盖,并将载体放置在样品舱中。
-选择适当的激发波长和发射波长,并将它们设置到仪器上。
-调节仪器上的曝光时间,以确保荧光强度在仪器的线性范围内。
5.数据分析测量完成后,需要对数据进行分析:-使用仪器上的软件导出数据,并存储到计算机中。
-对数据进行统计分析,如计算平均值、标准差等。
-通过比较样品间的荧光强度,得出相应的结论。
6.清洁和维护在使用荧光定量仪完成实验后,需要进行仪器的清洁和维护工作:-关闭仪器电源,并拔下电源线。
-将使用过的载体和滤光片取下,并进行清洗。
-清洁仪器的外壳和光学系统,可以使用干净的纸巾或专门的清洁剂。
注意事项:-避免直接接触荧光管,以免对其造成损坏。
-在测量荧光强度之前,应先调节仪器的对比度和亮度,以获得清晰的图像。
-在测量过程中,尽量避免光线干扰,可在实验室内提供充足的遮光条件。
总结:以上是荧光定量仪的操作指南。
正确操作荧光定量仪是确保实验结果准确的重要步骤,希望本文对您在实验中使用荧光定量仪时有所帮助。

实时荧光定量PCR仪操作规程1. 开始运行仪器打开电脑;打开定量PCR仪底座开关;启动CFX Manager软件。
2. 放置样品将PCR反应体系加入到0.2ml低缘八联管,盖上管盖;或加入低缘96孔板,用光学级封膜封好。
注意,必须带一次性塑料手套,不要让手指接触到反应管表面。
将反应管按顺序放入仪器的加热孔中。
3. 设置程序,运行实验定量PCR软件操作基本步骤为:a. 设置热循环程序文件(Protocol Tab);b.设置反应板文件(Plate Tab);c.点击“Start Run”键,运行程序;热循环程序文件(Protocol Tab)设置指南:点击Edit(编辑)或 Create New(创建新程序);反应板设置文件(Plate Tab)设置指南:选择本次实验所要使用的荧光染料种类;单击样品类型;如要某些反应孔第一荧光染料对应的样品类型为标准品(Standard),点击“Dilution Series”键可设置其标准品浓度及稀释倍数;点击“Start Run”键。
单击open lid(打开热盖)或Close lid(关闭热盖)放置样品;单击Start Run,保存文件,开始运行程序。
4. 结果分析PCR反应结束后,软件会自动计算标准曲线和Ct值等。
如需进行表达量分析、等位基因分析等,在软件窗口选择相应分析功能。
点击右上方的“Report”键,还可输出结果报告单。
5. 关闭运行仪器实验结束后取出反应管,顺序关闭CFX Manager软件、定量PCR仪电源,关闭电脑。
注意事项:CFX仪器上盖部分为全自动控制,在通电状态,严禁任何人为干涉上盖开启或关闭的行为,此类行为会导致上盖故障,危及仪器使用。

荧光定量PCR仪使用方法
(1)开机:荧光定量PCR仪、与之相连的电脑
(2)放样:点击PCR仪上的“Eject”,放入已离心过的八连管样品,再缓慢关闭接样台。
(3)点击电脑上的“E盘”,找到“qRT-PCR“文件夹,找到相对应的应用程序,如做蓝耳,就选择”PRRSV”文件夹中的程序;腹泻则为“PEDV”.
(4)编辑:点开任一程序后,点击“Sample Editor“编辑所放样品的地址以及信息。
(5)存档:点击“File“选择”Saveas“,存到相对应的文件夹;务必修改名称(日期、时间)。
(6)传出:打开编辑好的程序,点击“T ool”→“Instrument Manager”,待灯变绿后(5-7s),再点击“Send/Receive Experiment”,找到要运行的程序,再点击>,便传到荧光定量PCR仪上。
(7)运行:选中荧光定量PCR仪上要工作的程序,点击“Start”开始工作。
(8)传入:待PCR结束后,打开运行程序,点击“T ool”→“Instrument Manager”,待灯变绿后(5-7s),再点击“Send/Receive Experiment”,选中相对应的文件夹,找到已结束程序,再点击<,便传到电脑上。
(9)实验结果分析:点击已保存已完成的程序,点击“Analysis”,便可进行实验结果的分析。
(10)关机:点击PCR仪上“Eject”,取出八连管;点“Exit”→”YES’退出,关闭电源,拔下插头即可。
另用专用塑料袋套上,以免灰尘侵入缩短使用寿命。

实时荧光定量PCR具体实验步骤
实时荧光定量(Real Time quantitative PCR)是检测RNA或DNA的一种常用技术,通过检测特定目标的增加(或减少),可以用来测定RNA 或DNA的表达水平,或者基因等的转录水平。
下面我们就对实时荧光定量PCR(RT-qPCR)的实验步骤进行具体介绍。
1.搭建实验
第一步是搭建实验,即准备实验所需的干燥试剂,第二步是准备RNA 样本,第三步是准备标准曲线,最后是根据实验需要准备实验板和实验试管。
2、RNA样品提取
在实验中,会使用到多种RNAs,一般情况下使用TRIzol或Phenol 抽提方法进行RNA抽提,不同的细胞、组织中RNA的杂质含量不一样,因此需要根据实验需求进行适当调整抽提浓度。
3、RT-qPCR反转录
在RT-qPCR反转录之前,首先要准备反转录试剂,一般采用qPCR反转录试剂盒,这种试剂盒含有足够的反转录荧光探针以及反转录引物,它可以有效帮助反转录过程。
反转录过程通过复制DNA片段的过程完成,最终转录出的cDNA存在细胞核中。
4、qPCR扩增实验
qPCR扩增实验是在反转录完成后进行,一般来说,这个步骤可以采用qPCR扩增试剂盒,该试剂盒中包含所需的扩增物质如DNA聚合酶、前驱核苷酸、dNTPs,检测细胞核中的cDNA。

PCR仪的使用步骤及原理引言聚合酶链式反应(Polymerase Chain Reaction,简称PCR)是一种在分子生物学研究中广泛应用的技术。
PCR仪作为PCR操作的关键工具,能够快速无误地扩增目标DNA 序列,为科学研究和临床诊断提供了重要的支持。
本文将介绍PCR仪的使用步骤及原理。
PCR仪的使用步骤以下是PCR仪的使用步骤:步骤一:准备反应体系1.准备PCR反应液,包括DNA模板、引物、核酸酶、缓冲液等。
2.将反应液分配到PCR试管中,确保每个试管的反应体系一致。
3.在一个试管中加入水作为空白对照。
步骤二:设置PCR仪的程序1.打开PCR仪,确保仪器处于正常工作状态。
2.设置PCR仪的反应程序,包括温度、时间等参数。
根据不同的PCR实验设计,设置合适的程序。
步骤三:装载样品1.将准备好的PCR试管放置在PCR仪的样品架上。
2.检查样品架是否放置正确,确保试管紧密接触PCR仪的加热块。
步骤四:运行PCR程序1.关闭PCR仪的盖子,启动程序运行。
2.PCR仪将根据设定的程序依次进行加热、变性、退火和延伸等反应步骤。
3.在PCR反应结束后,PCR仪会保持在设定温度,以保持PCR产物的稳定。
步骤五:PCR产物分析1.关闭PCR仪的电源,打开PCR试管。
2.可通过凝胶电泳、PCR产物可视化试剂等方法对PCR产物进行分析。
3.根据实验需求,进一步处理PCR产物。
PCR仪的原理PCR仪采用了温度循环技术,利用特定的酶(聚合酶)和核酸引物来引导DNA链的复制。
其原理主要包括以下三个步骤:1.变性(Denaturation):通过升高温度(通常为95℃),使DNA双链分离成两条单链DNA。
2.引物结合(Annealing):降低温度(通常为55-60℃),使引物与目标序列的单链DNA互补结合。
3.延伸(Extension):增加温度(通常为72℃),使聚合酶在引物的引导下合成新的DNA链。
通过不断重复这三个步骤,PCR仪可以在短时间内扩增特定的DNA序列。

实时荧光定量PCR详细操作步骤流程!原理实时荧光定量PCR技术,是指在PCR反应体系中加入荧光基团,利用荧光信号积累实时监测整个PCR进程,最后通过标准曲线对未知模板进行定量分析的方法。
步骤一、样品RNA的抽提1. 取冻存已裂解的细胞,室温放置5分钟使其完全溶解。
2. 两相分离每1 ml的TRIZOL试剂裂解的样品中加入0.2 ml的氯仿,盖紧管盖。
手动剧烈振荡管体15秒后,15到30℃孵育2到3分钟。
4℃下12 000 rpm离心15分钟。
离心后混合液体将分为下层的红色酚氯仿相,中间层以及无色水相上层。
RNA全部被分配于水相中。
水相上层的体积大约是匀浆时加入的TRIZOL试剂的60%。
3. RNA沉淀将水相上层转移到一干净无RNA酶的离心管中。
加等体积异丙醇混合以沉淀其中的RNA,混匀后15到30℃孵育10分钟后,于4℃下12 000 rpm 离心10分钟。
此时离心前不可见的RNA 沉淀将在管底部和侧壁上形成胶状沉淀块。
4. RNA清洗移去上清液,每1 mlTRIZOL试剂裂解的样品中加入至少1 ml的75%乙醇(75%乙醇用DEPCH2O配制),清洗RNA 沉淀。
混匀后,4℃下7 000 rpm离心5分钟。
5. RNA干燥小心吸去大部分乙醇溶液,使RNA沉淀在室温空气中干燥5-10分钟。
6. 溶解RNA沉淀溶解RNA时,先加入无RNA酶的水4 0ul用枪反复吹打几次,使其完全溶解,获得的RNA溶液保存于-80℃待用。
二、 RNA质量检测1. 紫外吸收法测定先用稀释用的TE溶液将分光光度计调零。
然后取少量RNA溶液用TE稀释(1:100)后,读取其在分光光度计260nm和280nm处的吸收值,测定RNA溶液浓度和纯度。
(1)浓度测定A260下读值为1表示40 ug RNA/ml。
样品RNA浓度(μg/ml)计算公式为:A260 x 稀释倍数 x 40 ug/ml。
具体计算如下:RNA溶于40 ul DEPC水中,取5 ul,1:100稀释至495 ul的TE 中,测得A260 = 0.21RNA 浓度= 0.21 x 100 x 40 ug/ml = 840 ug/ml 或 0.84 ug/ul 取5 ul用来测量以后,剩余样品RNA为35 ul,剩余RNA总量为:35 ul x 0.84 ug/ul = 29.4 ug(2)纯度检测RNA溶液的A260/A280的比值即为RNA纯度,比值范围1.8到2.1。

实时荧光定量PCR具体实验步骤1.提取样本RNA/DNA:首先,从研究对象中提取出所需的RNA或DNA样本。
可以使用商业化的提取试剂盒来完成这一步骤。
2. 反转录酶链反应(RT):如果提取的样本为RNA,则需要先进行反转录酶链反应,将RNA转录成cDNA(即DNA拷贝),反转录酶具有多样性(M-MLV逆转录酶)和过程性(RTase)。
3.准备PCR反应体系:根据实验所需的扩增模板和引物,将PCR反应体系按照厂家提供的信息制备,通常需要包括PCR反应缓冲液、dNTPs、引物、酶、模板DNA/cDNA和稀释水。
4. 调整荧光探针的浓度:如果实验中使用到了荧光探针(如TaqMan探针、MGB探针等),需要根据实验要求对荧光探针的浓度进行调整。
5.放置PCR板:将所需的PCR试管或板放置在适当的位置,以便加载反应体系。
6.反应体系加载:按照实验所需的样品数量和模板浓度,依次向PCR反应管或板中加入反应体系。
注意,需要设置相应的阳性对照和阴性对照。
7.封闭PCR反应管/板:闭合PCR反应管或板,以防止反应体系的挥发和样品的交叉污染。
8.准备PCR仪:根据PCR仪的要求,调整PCR仪的温度和时间参数。
9.PCR扩增:将已封闭的PCR反应管或板放置在预热的PCR仪中,开始PCR扩增。
根据实验需要,设置不同的PCR程序(如热启动PCR、两步PCR和三步PCR等)。
10. 实时监测PCR过程:在PCR反应过程中,实时监测PCR反应管或板中产生的荧光信号,并记录下每个周期(cycle)的荧光值。
11. 数据分析:根据荧光信号的变化,结合标准曲线法或相对表达量法,对PCR反应中目标序列的数量进行定量分析。
常见的分析软件包括Stratagene MxPro QPCR软件和Applied Biosystems SDS软件等。
12.结果分析和解释:根据数据分析的结果,对实验结果进行解释和讨论,并在图表中呈现。
13. 结果验证:可以使用其他方法验证RT-qPCR的结果,如Western blotting、细胞免疫化学分析等。

ViiATM 7 Dx荧光定量PCR仪操作规程Ⅰ. 目的描述ViiATM 7 Dx荧光定量PCR仪的使用和一般维护的标准操作规程。
Ⅱ. 范围适用于ViiATM 7 Dx荧光定量PCR仪的使用和维护。
Ⅲ. 职责由研究所制定程序性文件,所主任负责监督实施。
Ⅳ. 规程1 打开ViiATM 7 Dx仪器:1.1 拨动ViiATM 7 Dx仪器后面的电源开关,然后等待仪器初始化。
(注:当触摸屏显示Main Menu时,ViiATM 7 Dx仪器准备就绪,可以使用。
)1.2 打开ViiATM 7 Dx仪器计算机:1.2.1 按下计算机的电源按钮,然后等待计算机初始化。
1.2.2 当Login屏幕出现时,输入用户名和密码,然后单击OK。
1.2.3 在桌面上,双击ViiATM 7 Dx Sofeware。
(或选择Start→All Programs→Applied Biosystems →ViiATM 7 Dx Instrument→ViiATM 7 Dx Software.)2 关闭ViiATM 7 Dx仪器:不使用时,Applied Biosystems ViiATM 7 Dx实时PCR仪在低功率模式下进行;然而,ViiATM 7 Dx仪器可以完全断开电源,从而部件没有电源。
2.1 关闭ViiATM 7 Dx仪器:2.1.1如果ViiATM 7 Dx仪器触摸屏不是空白,触摸以使仪器置于待机模式。
2.1.2拨动ViiATM 7 Dx仪器后面的电源开关。
2.2 关闭ViiATM 7 Dx仪器计算机:在桌面,选择Start→Shut Down。
3 保存ViiATM 7 Dx仪器:Applied Biosystems ViiATM 7 Dx实时PCR仪可以长时间断开电源和保存。
停用时间长度决定您断开ViiATM 7 Dx仪器电源的方法。
3.1 所需要的材料:MicroAmp Optical 384孔反应板(在运输期间或超过1周的停用期间,空白板能够保护ViiATM 7 Dx仪器的内部部件)。

实时荧光定量PCR仪操作流程实时荧光定量PCR(Polymerase Chain Reaction)仪是一种常用的分子生物学实验仪器,用于定量检测DNA或RNA样本中的特定序列。
通过对PCR反应进行荧光检测,可以实时监测目标序列的扩增过程,并且具有高灵敏度和高特异性的优势。
下面将介绍实时荧光定量PCR 仪的操作流程,以帮助您正确进行实验。
1. 准备工作在开始实时荧光定量PCR实验之前,需要准备以下实验器材和试剂:(1)实时荧光定量PCR仪:确保仪器已预热至适当的温度;(2)PCR反应管或板:根据实验需要选择适当的规格;(3)PCR试剂盒:包括DNA模板、引物、探针、酶等;(4)DNA/RNA样本:按照实验设计合理稀释或提取,确保样本质量良好;(5)聚合酶链式反应混合液(PCR Mix):根据试剂盒说明配置混合液。
2. 操作步骤(1)设置PCR仪参数:将需要的实验参数输入PCR仪中,包括扩增阶段的温度、时间和循环次数等。
(2)制备PCR反应体系:按照试剂盒说明书中的配方将PCR Mix、DNA模板、引物和探针等加入PCR反应管或板中。
(3)密封反应管或板:确保反应管或板密封良好,避免样品蒸发或污染。
(4)放入PCR仪:将密封好的PCR反应管或板放入PCR仪中,确保仪器已预热至适当的温度。
(5)运行实验:启动PCR仪,开始实时荧光定量PCR反应。
仪器会根据设置的参数自动进行温度循环和荧光信号监测。
(6)数据分析:实验进行过程中,可以通过PCR仪的软件实时监测扩增曲线和荧光信号,获得相关的实验数据。
(7)结果解读:根据实验目的和结果,对荧光信号和扩增曲线进行分析和解读,获得所需的定量PCR结果。
3. 注意事项(1)实验操作应按照严格的无菌操作要求进行,避免PCR反应受到外部污染。
(2)实时荧光定量PCR仪涉及的试剂和标本具有一定的生物安全风险,应按照相关安全规范进行操作和处理。
(3)准确的数据记录和标注是保证实验结果可靠性的重要环节,务必在实验过程中进行详细记录。
荧光定量PCR仪操作规程1.开机程序(1)打开电脑,进入桌面。
(2)打开PCR仪器的电源开关(注:该仪器有两个电源开关,一个控制PCR 仪,一个控制光源系统)。
(3)双击桌面上的软件图标,点击“yes”,进入软件的主菜单。
(4)或打开开关,视窗上显示“SELF TEST”,显示10秒中后,显示RUN-ENTER 菜单:“RUN ENTER PROGRAM”准备执行程序。
2.关机程序(1) 保存数据,退出软件的主菜单。
(2) 关掉电脑,关闭PCR仪器的电源开关。
3.程序文件的设置及打开(1)实验程序已预先设定点击软件左方主目录中的“Library”,进入该界面后。
选择“View Protocol”页面,根据路径,找到预存的程序文件。
放入样本管,关紧盖子。
运行已经编好的程序,则直接按《Proceed》,用箭头键选择已储存的程序,按《Proceed》,则屏幕显示:“-ENABLE DISABLE HEATED LID” 按《Proceed》选择ENABLE,则开始执行程序。
(2)创建新的程序文件点击软件左方主目录中的“Workshop”,进入该界面。
选择“Edit Protocol”页面,输入相应的温度、时间、重复的循环数(Repeats),增加或删除步骤(Cycle和Step),在“Select data collection step(s)”中选择需要进行荧光收集的步骤。
完成后,在“Protocol Filename”中输入程序的文件名,点击“Save this protocol”。
如果要输入新的程序,则在RUN-ENTER菜单上用箭头键选择ENTER PROGRAM,按《Proceed》,屏幕显示“ -NEW LIST EDIT DELET”,按《Proceed》,1)选择NEW,命名新的程序,最多8个字母,输入后按《Proceed》确认。
输入程序步骤:名字输入后,显示“ STEP1TEMP GOTO OPITON END”,按《Proceed》则可以输入温度(0~100℃),按《Proceed》确认后,则可以输入孵育时间,用《Select》键移动光标,输入数字,完成后按《Proceed》确认,跳到下一步,输入方式同上。
pcr仪操作流程一、概述PCR(Polymerase Chain Reaction)是一种基于DNA复制原理的重要分子生物学技术,广泛应用于基因测序、基因表达分析、病原体检测等领域。
PCR仪作为PCR技术的核心设备之一,在实验室中扮演着至关重要的角色。
本文将介绍PCR仪的操作流程,以帮助读者更好地掌握PCR实验技术。
二、实验前准备1.检查PCR仪的电源及温控系统,确保其正常工作。
2.准备所需的PCR试剂和反应物,包括DNA模板、引物、dNTPs等。
3.准备PCR试剂的稀释液,如缓冲液、酶的稀释液等。
4.预先检查PCR仪的反应管和盖帽,确保其清洁,避免污染。
三、PCR反应体系的配制1.根据实验需要,计算反应的体积和浓度。
2.准备PCR反应试管,将所需的试剂依次加入,注意按照一定的顺序和技巧,避免交叉污染。
3.根据试管上的标记,轻轻混匀反应液,确保各试剂充分混合。
四、PCR仪的设置1.将反应管放入PCR仪的样品架中,注意要保持反应管的平衡稳定。
2.打开PCR仪的电源,确保温控系统的正常工作。
3.设置PCR反应的温度和时间,包括退火、延伸和变性等步骤。
根据实验的需要和PCR引物的特性,合理设置反应参数。
五、PCR反应的运行1.在PCR仪界面上点击“开始”或类似的按钮,启动PCR反应。
2.监控PCR反应的过程,注意观察PCR仪上显示的温度、时间等参数,确保反应的正常进行。
3.完成PCR反应后,关闭PCR仪的电源,取出反应管。
六、PCR产物的分析与保存1.取出PCR反应产生的反应管,并进行相应的分析检测。
常见的分析方法包括凝胶电泳、测序、聚合酶链式反应等。
2.将PCR产物进行保存,可以冷冻保存或进行后续实验操作。
七、实验后清理1.关闭PCR仪的电源,等待其冷却后,进行清理。
2.将使用过的反应管和其他废弃物进行分类处理,避免交叉污染和环境污染。
八、注意事项1.操作过程中要注意无菌技术,避免污染。
2.注意试剂和反应物的储存条件和有效期,使用过期或存储不当的试剂可能影响实验结果。
实时荧光定量PCR仪快速操作指南1.连接电源从包装箱里取出仪器放置在实验台上,拿出电源线和电源适配器,将电源线一端与电源适配器相连,另一端连接至交流220V电源插座(AC85~264V)电源适配器的输出端连接到仪器电源插孔。
接口插入仪器电源插孔,注意插孔方向箭头方向朝上。
打开仪器背面的电源开关开启仪器,仪器自检成功,自动进入到软件界面。
2.样品准备◼准备试剂Q1600实时荧光定量PCR仪使用0.2ml透明离心试管根据试剂要求选用10-100μl合适的加液量。
◼离心操作配置完成试剂样本的试管在放入仪器之前,要用离心机进行离心操作,确保试剂液体处于试管底部,且液体内部不含有气泡。
◼放置样品将反应管按照顺序放入加热孔内。
3.设置程序,运行实验软件操作基本步骤:◼新建实验新建实验,选择运行槽◼基本设置设置实验名称,实验类型,检测项目,选择使用的染料。
◼样本设置设置样品名称,样本ID号,选择样本类型◼程序设置设置需要的反应程序◼保存文件单击保存,保存实验文件◼运行单击运行,运行实验。
4.结果分析◼实验结束,软件自动计算Ct值,根据判定规则自动出结果。
◼如需进行熔解分析和基因分型,在软件分析类型里选择相应的分析功能。
5.结果导出◼导出实验结果单击导出,导出实验数据。
◼结果打印连接配置的热敏打印机,选中要打印的样品孔,单击打印,打印实验结果。
6.关闭仪器◼实验结束,取出反应管◼长按仪器前面板关机按键,关闭仪器◼长时间不使用仪器,请关闭仪器背部左下角电源开关。
实时荧光定量PCR仪简易操作及注意事项
一、操作流程:
1、先打开电脑电源,待其开机完毕后,再打开与电脑相连的荧光定量PCR仪主机,等待两者连接成功;
2、点击仪器主机屏幕右下角的弹出/弹入按钮,打开反应板板槽,将反应板放在对应的位置上,再轻触按钮,关闭板槽;
3、单击电脑桌面上QuantStudioTM Real-Time PCR Software图标,运行荧光定量PCR分析软件;
4、根据实验自身要求,在设置中对反应板和相关参数进行设定;
5、待设置完毕后,点击软件界面中的START RUN按钮启动;
6、仪器运行完毕后,将主机中的反应板取出并根据需要将实验数据导出;
7、按照先仪器主机后电脑的次序,将彻底仪器关闭,后使用专用防尘布或防尘罩对主机进行防尘处理,并将放置仪器的工作台面整理干净。
二、注意事项:
1、每次使用仪器之前务必在实验记录本上进行详细登记,并告知管理员;
2、按先电脑后主机的次序开机,以避免两者不能成功连接;
3、使用U盘或者其他存储设备拷贝实验数据时,务必保证其不携带病毒软件;
4、在仪器使用过程中如遇到问题,请务必联系管理员进行处理;
5、每周要对仪器外部进行除尘操作,保持仪器表面清洁;
6、应避免仪器长时间搁置,如长时间不使用,应每隔一个月进行必要的开机运行,保证仪器状态良好;
7、如因操作人自身操作问题造成仪器损坏的,操作人须按价赔偿。
实时荧光定量PCR仪器操作规程
1.打开电脑,打开Bio-Rad iQ5电源和光路电源;
2.点击Bio-Rad iQ5图标,启动软件;
3.预热30分钟;
4.点击PROTOCAL键,点edit编辑,保存;
5.点击plate键,点edit编辑,保存;
6.根据所编辑的plate,将待扩增物放入样品槽中;
7.点击run set ,在界面右上角点击run;
8.点击begin run,运行;
9.待扩增完成后,点击result,分析数据;
10.关闭Bio-Rad iQ5软件;
11.关闭电脑及Bio-Rad iQ5电源;
注意事项
1.关闭仪器前应先关闭iQ5软禁啊,否则仪器会认为是因为故障停电而导致仪器
关闭,下次开机时,仪器会有自我保护功能;
2.实验前后都要填写仪器使用登记表,实验完成后填写仪器使用记录;
3.正确操作仪器,使用过程中如发现仪器出现异常情况,应及时与实验室管理人
员联系;
4.要求用托盘盛放药品,避免药品直接放在实验台上,实验结束及时清洁实验台,
带走所有实验试剂及样品;
5.仪器使用人员有义务打扫实验室卫生;
6.仪器使用人员有义务和责任负责实验室内实验仪器的安全;
7.仪器使用人员有义务和责任负责实验室内水、电安全;。
Applied Biosystems™ ViiA™ 7 实时定量PCR仪简明中文手册第三部分:基因分型英潍捷基(上海)贸易有限公司赛默飞世尔科技公司Applied Biosystems™ ViiA™ 7实时定量PCR仪1.双击桌面图标,或从Start > All programs > Applied Biosystems > ViiA 7 Software > ViiA 7 Software v1.2开启软件。
进入主界面后选择“Experiment Setup”。
2. 选择“Setup”下的“Experiment Properties”界面。
2.1 输入实验名称 (Experiment Name)。
2.2 确认Block类型。
2.3 选择基因分型实验类型,“Genotyping”。
2.4 选择试剂种类。
2.5 选择运行模式。
2.6 选择在定量仪器上进行预读板及扩增的过程。
3. 选择“Setup”下的“Define”界面,设置SNP检测位点和样品名称。
3.1 在“SNPs”下点击“Edit”或”New”,编辑或添加SNP检测位点。
在“SNPAssay Name”中填写待测SNP位点名称;在”Allele1/Allele2 Name”中输入待测位点的碱基名称;“Reporter”和“Quencher”中选择所标记的荧光基团及淬灭基团。
对于“Quencher”的选择,如果是MGB探针,请选择"NFQ-MGB";如果是TAMRA探针,请选择TAMRA;如果是其他形式的非荧光淬灭基团选择"None"。
3.2 在“Samples”下点击“New”,添加待测样品。
在“Sample Name”中编辑样品名称。
4. 选择“Setup”下的“Assign”界面,编辑样品板。
利用鼠标单选或拖拽以选择反应孔,然后勾选左侧的Markers及样本,同时在“Task”选项中指定该反应孔的类型(U代表未知样本,N代表阴性对照,1/1、2/2、1/2代表三种基因型的阳性对照)。
实时荧光定量PCR仪ViiA 7 操作步骤
——以RNase P示例实验为例
一、定义384孔样品模块的实验属性
打开电脑访问ViiA 7 软件,然后打开左侧仪器开关。
单击Experiment Setup图标。
单击Experiment Properties以访问Experiment Properties屏幕。
在ViiA 7 软件中设计RNase P实验示例时,请输入:
二、使用Define屏幕定义RNase P示例实验的目标基因、样品。
1. 单击Define以访问Define屏幕。
2. 定义目标基因
a. 单击New以增加和定义目标基因。
b. 在目标基因表中,单击Target Name列中的一个单元格,并输入:
c. (可选)单击Save以便将新增或原有的正在编辑的目标基因保存到Target Library。
d. 单击Add Saved从目标基因库添加目标基因。
3. 定义样品
a. 单击New以增加和命名样品。
b. 在样品表中,单击Sample Name列中的一个单元格,并输入:
c. (可选)单击Save以将新增或原有的正在编辑的样品保存到Sample Library。
d. 单击Add Saved从样品库添加样品。
4. (可选)定义生物学平行测定
a. 在Define Biological Replicates Groups表中,单击New以增加和命名生物学平行
测定组。
b. 从下拉菜单选择Color。
c. 单击Comments列,以便为该生物学平行测定组添加注释。
注:实验示例不使用生物学平行测定组。
保留Biological Replicate Groups空白。
5. 选择用作参比荧光的染料ROX。
三、分配目标基因、样品和生物学组
利用Assign(分配)屏幕将目标基因、样品和生物学平行测定组分配到RNase P实验示例反应板内的各孔。
注:您可以在不进行分配的情况下开始运行,但在扩增曲线中,将不会有实时数据(只有在您已经对板进行设置后,才可以见到扩增曲线)。
1. 单击Assign以访问Assign屏幕。
2. 定义并设置标准品。
a. 单击Assign屏幕上的Define and Set Up Standards(定义和设置标准品)。
b. 选择目标基因。
c. 定义标准曲线。
d. 为标准品选择和安排反应孔。
3. 目标基因和样品。
a. 利用Assign屏幕上的板布局或反应孔表选择反应孔。
b. 利用下拉菜单分配目标基因RNase P为其任务。
c. 选择您想要分配给所选反应孔的样品附近的复选框。
四、设置运行方法
利用Run Method屏幕为RNase P实验设置运行方法。
1. 单击Run Method以访问Run Method屏幕。
2. 为每个孔的反应体积输入1到20的数字。
对于下列消耗品,ViiA™ 7仪器支持的最
大反应体积如下:
① MicroAmp® Optical 384孔反应板–20μL
②微流体卡–1μL
3. 在Graphical View选项卡中:
①确保热循环扩增曲线适合您的试剂。
②如需要,可对默认的运行方法进行编辑,或用ViiA™ 7 Dx软件随附的运行方法
库中的一个运行方法代替默认运行方法。
③通过单击启用数据采集。
注:当需要对各阶段实时采集的数据进行分析时,启用数据采集特别有用。
④编辑升降温速度。
您可以增加或降低某一阶段的升降温速度。
⑤编辑PCR阶段
a. 更改PCR阶段的循环次数。
b. 选择Enable AutoDelta复选框以增加或降低后续各循环的温度和(或)保温
时间。
您还可以更改AutoDelta的起始循环。
启用AutoDelta后会显示图标。
单击AutoDelta Off图标以改变AutoDelta Settings对话框中循环阶段的
AutoDelta设置。
然后,单击Save Setting以显示AutoDelta On 图标。
五、开始实验
1. 触碰ViiA™ 7 Dx Instrument仪器触屏上的按钮,或单击ViiA 7软件
Instrument Console屏幕的Open Door,以从仪器侧面弹出板适配器。
2. 将反应板或微流体卡放到板适配器上。
确保反应板或微流体卡正确对齐。
①确保孔A1位于反应板或微流体卡托盘左上方的位置。
②确保反应板或微流体卡的条形码朝向仪器的前面。
3. 触碰ViiA™ 7 Dx Instrument仪器触屏上的按钮,或单击ViiA™ 7软件
Instrument Console屏幕的Close Door,以将板适配器收回。
六、运行实验
1. 在ViiA™ 7 软件中,单击导航窗格中的Run(运行)。
2. 单击START RUN开始运行实验。